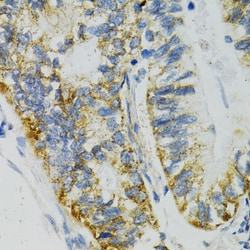
Invitrogen SLC27A2 Polyclonal Antibody 100 &mu;L; Unconjugated:Antibodies,
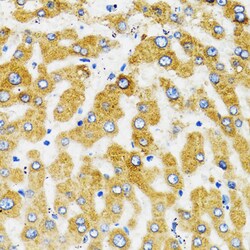
Invitrogen SLC27A2 Polyclonal Antibody 100 &mu;L; Unconjugated:Antibodies,

Learn More
Invitrogen™ SLC27A2 Polyclonal Antibody


Rabbit Polyclonal Antibody
Brand: Invitrogen™ PA588033
Description
Immunogen sequence: TKFSASQFWD DCRKYNVTVI QYIGELLRYL CNSPQKPNDR DHKVRLALGN GLRGDVWRQF VKRFGDICIY EFYAATEGNI GFMNYARKVG AVGRVNYLQK KIITYDLIKY DVEKDEPVRD ENGYCVRVPK GEVGLLVCKI TQLTPFNGYA GAKAQTEKKK LRDVFKKGDL YFNSGDLLMV DHENFIYFHD RVGDTFRWKG ENVATTEVAD TVGLVDFVQE VNVYGVHVPD HEGRIGMASI KMKENHEFDG KKLFQHIADY LPSYARPRFL RIQDTIEITG TFKH Positive Samples: HepG2; Cellular Location: Endoplasmic reticulum membrane, Multi-pass membrane protein, Peroxisome membrane.
The protein encoded by this gene is an isozyme of long-chain fatty-acid-coenzyme A ligase family. Although differing in substrate specificity, subcellular localization, and tissue distribution, all isozymes of this family convert free long-chain fatty acids into fatty acyl-CoA esters, and thereby play a key role in lipid biosynthesis and fatty acid degradation. This isozyme activates long-chain, branched-chain and very-long-chain fatty acids containing 22 or more carbons to their CoA derivatives. It is expressed primarily in liver and kidney, and is present in both endoplasmic reticulum and peroxisomes but not in mitochondria. Its decreased peroxisomal enzyme activity is in part responsible for the biochemical pathology in X-linked adrenoleukodystrophy.
Specifications
| SLC27A2 | |
| Polyclonal | |
| Unconjugated | |
| SLC27A2 | |
| ACSVL1; Arachidonate--CoA ligase; Facvl1; FATP2; FATP-2; Fatty acid transport protein 2; fatty acid transporter; fatty-acid-coenzyme A ligase, very long-chain 1; hFACVL1; HsT17226; Long-chain-fatty-acid--CoA ligase; Phytanate--CoA ligase; SLC27A2; solute carrier family 27 (fatty acid transporter) member 2; solute carrier family 27 (fatty acid transporter), member 2; solute carrier family 27 (fatty acid transporter), member 32; solute carrier family 27 member 2; THCA-CoA ligase; ve; very long-chain acyl-CoA synthetase; very long-chain acyl-Coenzyme A dehydrogenase synthase; very long-chain fatty-acid-coenzyme A ligase 1; very long-chain-fatty-acid-CoA ligase; very-long-chain acyl-CoA synthetase; Vlac; VLACS; Vlcs | |
| Rabbit | |
| Affinity Chromatography | |
| RUO | |
| 11001, 26458, 65192 | |
| -20°C, Avoid Freeze/Thaw Cycles | |
| Liquid |
| ELISA, Immunohistochemistry (Paraffin), Western Blot, Immunocytochemistry | |
| 1.65 mg/mL | |
| PBS with 50% glycerol and 0.09% sodium azide; pH 7.3 | |
| O14975, O35488, P97524 | |
| SLC27A2 | |
| Recombinant fusion protein containing a sequence corresponding to amino acids 290-573 of human FATP2 (NP_0036362). | |
| 100 μL | |
| Primary | |
| Human, Mouse, Rat | |
| Antibody | |
| IgG |
Your input is important to us. Please complete this form to provide feedback related to the content on this product.